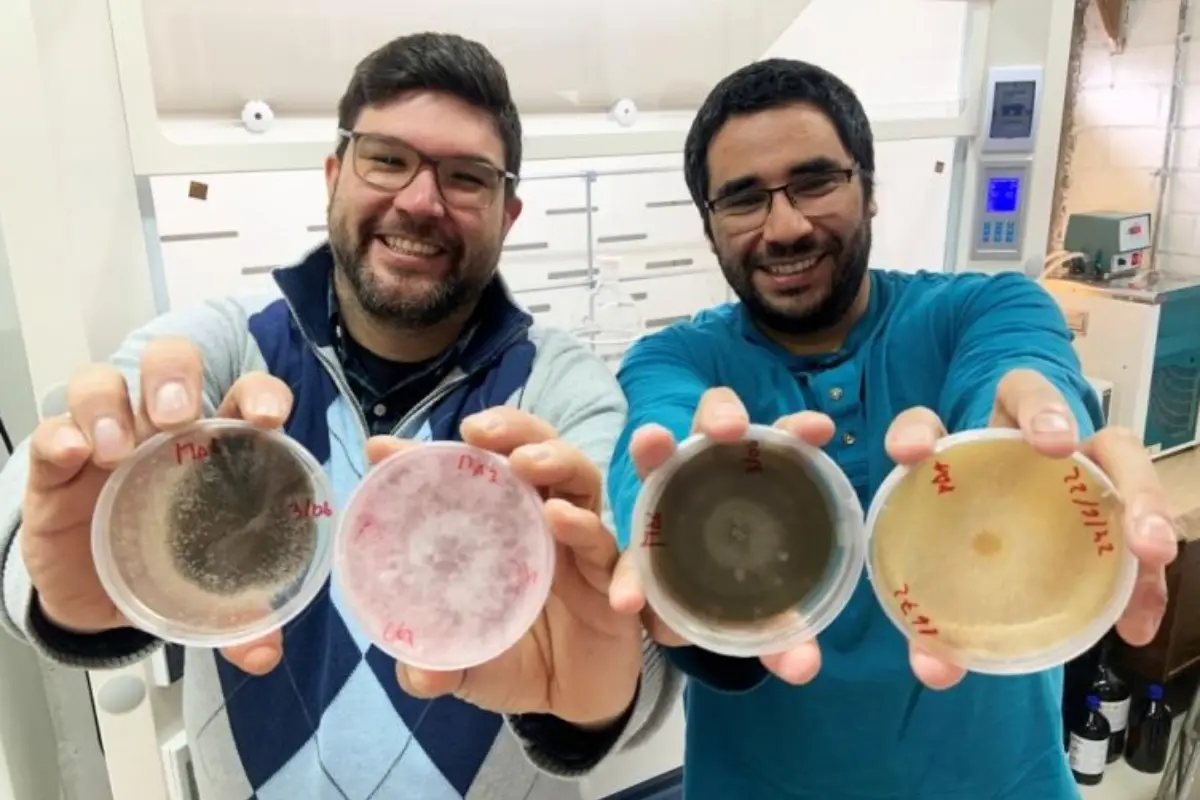
Investigadores

Horóscopo viernes 19 de diciembre: Predicciones de Yolanda Sultana
Revisa las predicciones en salud, dinero y amor de cada signo zodiacal de la mano de Yolanda Sultana.
La investigación que busca controlar el Alzheimer, estará a cargo de los científicos Jaime Cabrera y Ramón Ahumada, académicos de la Universidad del Bío-Bío .
Los investigadores Jaime Cabrera Pardo (37 años) y Ramón Ahumada Rudolph (38 años) del Departamento de Química de la Universidad del Bío-Bío (UBB) viajarán en enero del 2023 a la Antártica para recolectar muestras de hongos que controlen el alzheimer.
El objetivo de esta investigación en la región más austral de Chile es encontrar la posibilidad de aislar microorganismos que habitan en condiciones extremas e inexploradas que ofrece precisamente la Antártica, los que producen distintas moléculas con características y potencialidades únicas.
El doctor de Química Orgánica de la Universidad de Chicago (USA) y postdoctorado en la Universidad de Cambridge, Jaime Cabrera Pardo, indicó que "actualmente la comunidad científica está reuniendo esfuerzos para desarrollar nuevos compuestos naturales efectivos, con el fin de retrasar el inicio y desarrollo del alzheimer, junto a otras patologías neurodegenerativas".
"Se ha demostrado que algunos hongos de zonas prístinas y condiciones extremófilas de la Antártica tienen un alto potencial de ejercer un efecto neuroprotector, lo que constituye una gran reserva de posibles fármacos y agentes nutracéuticos”, añadió.

A través de Twitter el observatorio astronómico más grande del mundo confirmó el ataque cibernético, el cual afectó sus sistemas el pasado 29 de octubre.
Los científicos chilenos realizarán su estudio de investigación durante 12 días, donde pretenden recolectar distintas muestras, tales como: sustratos vegetales, sedimientos, suelo y agua de mar, las que se irán procesando en el laboratorio microbiológico de la Base Científica Profesor Julio Escudero, en la Antártica.
Las enfermedades neurodegenerativas son uno de los retos socio-sanitarios más actuales dentro de la sociedad, donde el alzheimer es uno de los más prevalentes hasta ahora.
Esta patología se caracteriza por un deterioro cerebral, el cual culmina con un daño cognitivo y trastornos del comportamiento en la persona.
Según las estimaciones a nivel mundial, más de 40 millones de personas padecen actualmente un tipo de demencia. En la población chilena, el 1% cuenta con una de estas enfermedades neurodegenerativas, sin embargo, la cifra se incrementa hasta un 7% en la población mayor de 60 años de edad.
Revisa las predicciones en salud, dinero y amor de cada signo zodiacal de la mano de Yolanda Sultana.
El caso fue cerrado en diciembre de 2024, pero la familia de la víctima descubrió un nuevo antecedente.
El voluntario de 36 años quedó atrapado entre los escombros, tras un fatídico derrumbe.
